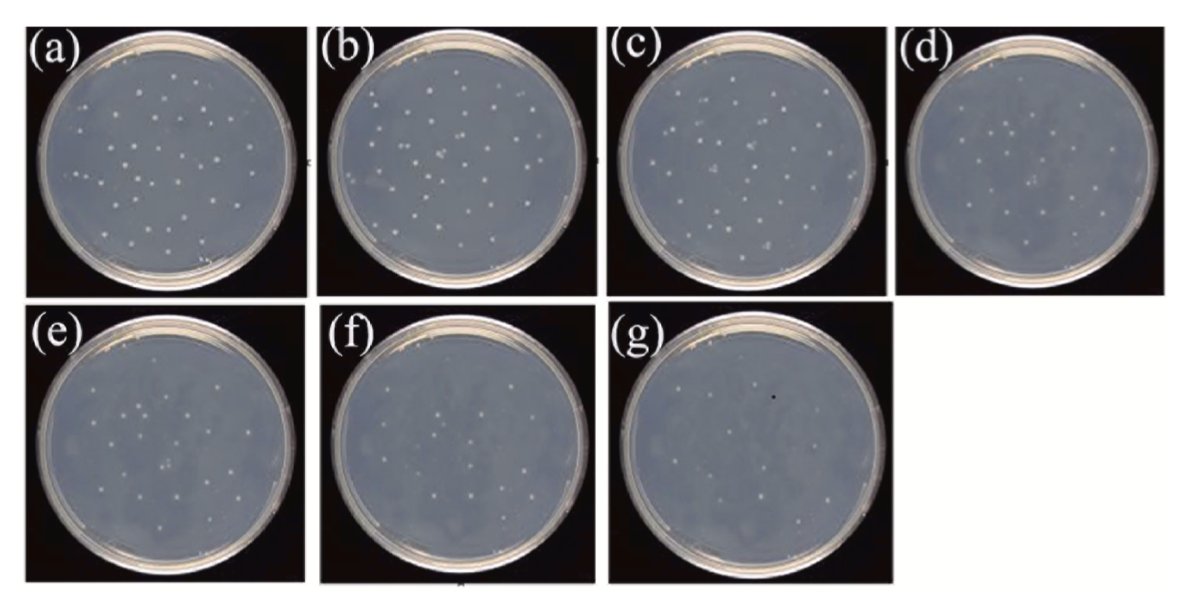
Elisabeth Bik tweet media

@Cmonmyboi @physicsJ Yes, third-reflection rainbows emerge from the raindrops in roughly the same direction as the incident sunlight. But they are faint and diffuse and hard to see against the sun.
English
David Ansley ☕
3K posts

@ConsumerDavid
I’ve worn a lot of hats. Now I’m just sharing a few of my photos. Enjoy!

Prenuvo, a startup selling elective whole-body MRI scans is launching a 10-year, 100,000 person study to prove its medical value. trib.al/ZyARy8m



















